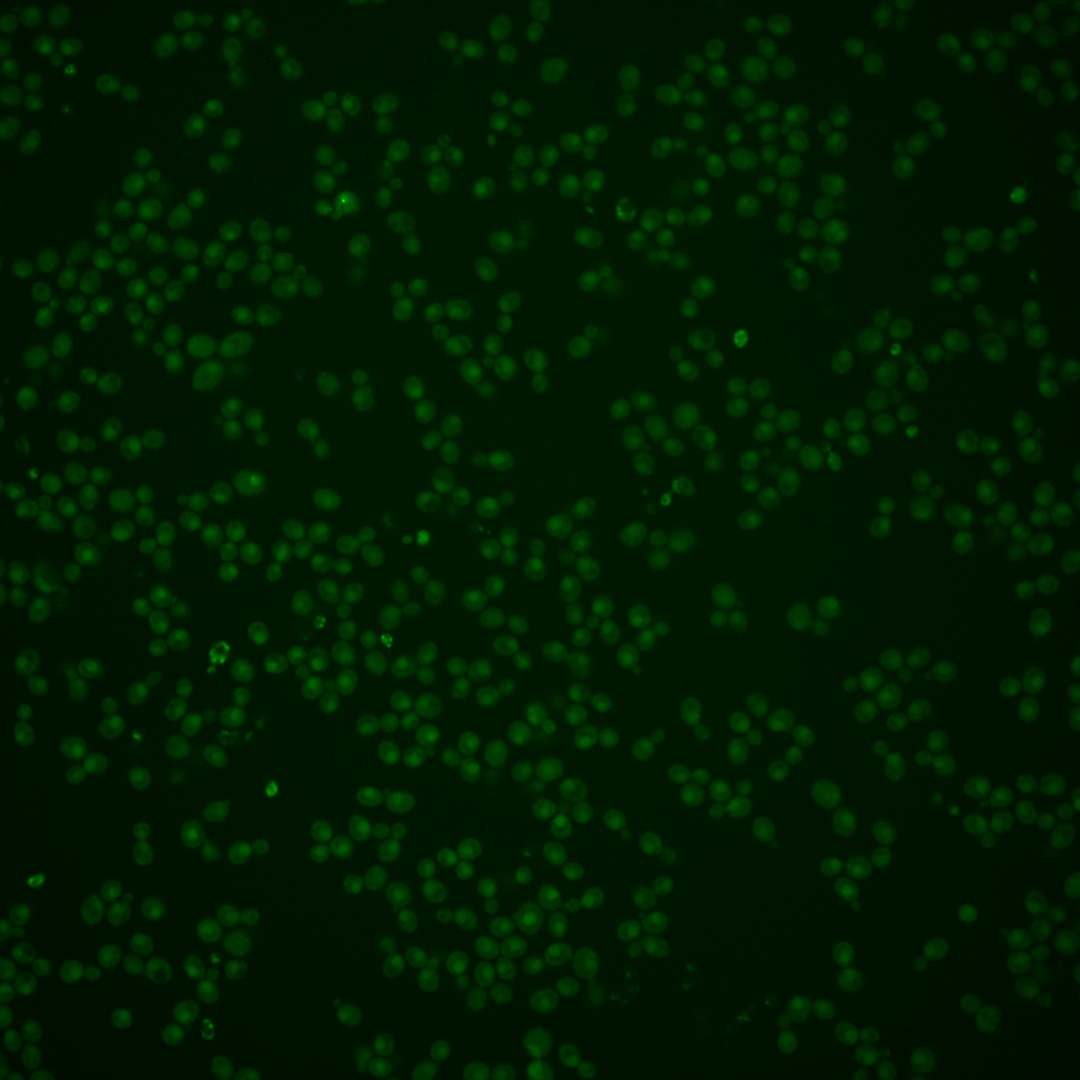
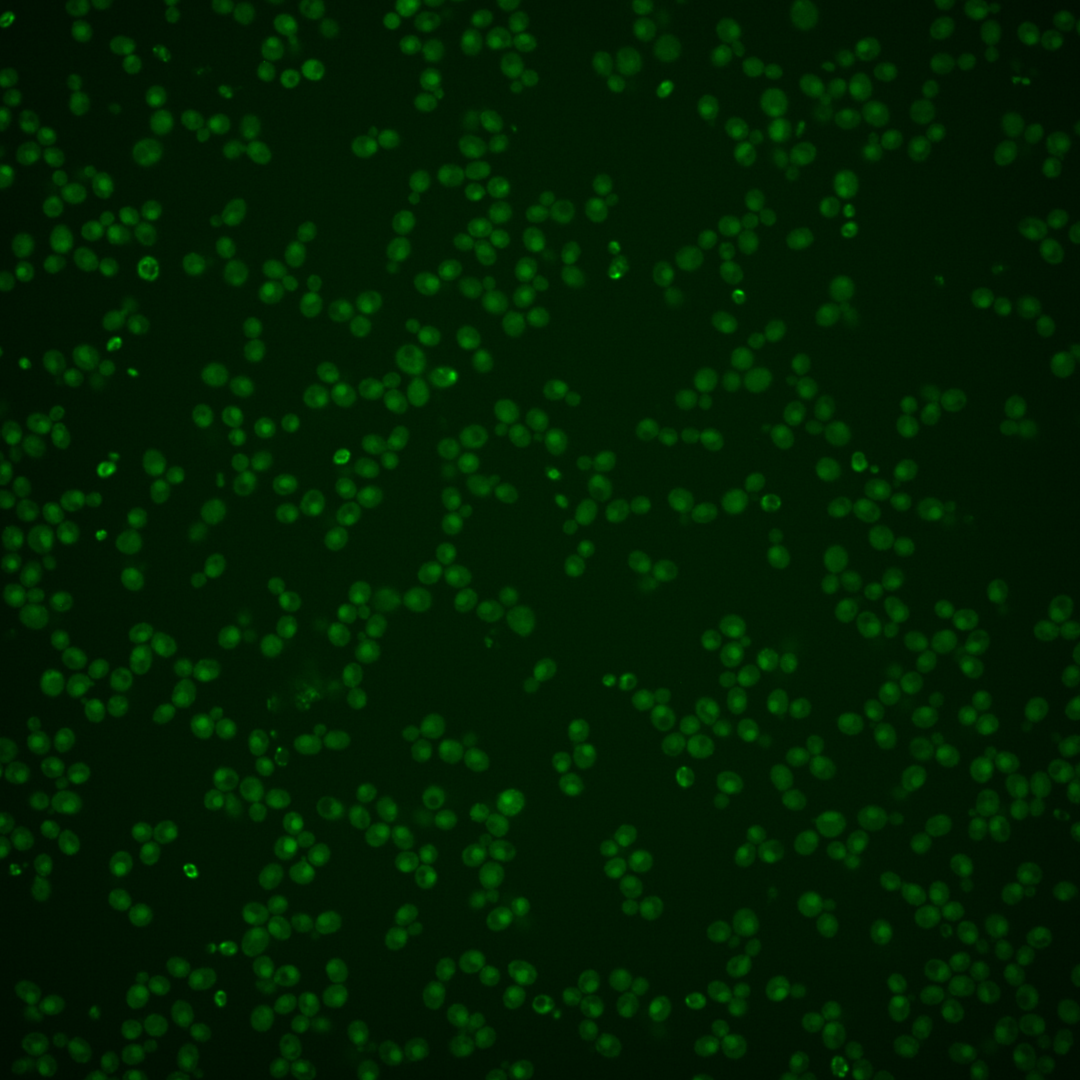

| Standard name | |
|---|---|
| Human Ortholog | |
| Description | Serine-threonine kinase and endoribonuclease; transmembrane protein that mediates the unfolded protein response (UPR) by regulating Hac1p synthesis through HAC1 mRNA splicing; role in homeostatic adaptation to ER stress; Kar2p binds inactive Ire1p and releases from it upon ER stress |
Micrographs




















































































Sub-cellular Localization
Yeast GFP Assignment
Protein Abundance
Localization Change
External localization resources
| ensLOC | DeepLoc | |||||||||||||||||||||||
|---|---|---|---|---|---|---|---|---|---|---|---|---|---|---|---|---|---|---|---|---|---|---|---|---|
| Localization | WT1 | WT2 | WT3 | RAP60 | RAP140 | RAP220 | RAP300 | RAP380 | RAP460 | RAP540 | RAP620 | RAP700 | HU80 | HU120 | HU160 | rpd3Δ_1 | rpd3Δ_2 | rpd3Δ_3 | WT1 | WT2 | WT3 | AF100 | AF140 | AF180 |
| Cortical Patches | 2 | 1 | 4 | 3 | 2 | 3 | 0 | 2 | 2 | 1 | 1 | 6 | – | 0 | 0 | – | – | 0 | 9 | 5 | 18 | 3 | 14 | 24 |
| Bud | 2 | 1 | 5 | 11 | 5 | 9 | 11 | 22 | 15 | 29 | 29 | 21 | – | 0 | 0 | – | – | 2 | 3 | 0 | 2 | 1 | 0 | 3 |
| Bud Neck | 1 | 0 | 0 | 0 | 0 | 0 | 0 | 0 | 0 | 0 | 1 | 0 | – | 0 | 1 | – | – | 4 | 13 | 10 | 6 | 5 | 4 | 10 |
| Bud Site | 0 | 0 | 0 | 0 | 0 | 1 | 0 | 0 | 1 | 2 | 1 | 1 | – | 0 | 0 | – | – | 0 | – | – | – | – | – | – |
| Cell Periphery | 5 | 4 | 11 | 13 | 16 | 19 | 14 | 8 | 14 | 13 | 11 | 16 | – | 4 | 15 | – | – | 9 | 2 | 3 | 8 | 5 | 10 | 16 |
| Cytoplasm | 311 | 165 | 262 | 202 | 289 | 249 | 312 | 359 | 220 | 364 | 239 | 260 | – | 36 | 116 | – | – | 422 | 139 | 77 | 21 | 21 | 36 | 36 |
| Endoplasmic Reticulum | 36 | 15 | 11 | 4 | 9 | 16 | 10 | 11 | 5 | 7 | 4 | 14 | – | 1 | 4 | – | – | 27 | 135 | 56 | 175 | 36 | 45 | 75 |
| Endosome | 0 | 1 | 12 | 10 | 16 | 8 | 14 | 27 | 6 | 8 | 3 | 6 | – | 0 | 0 | – | – | 3 | 2 | 3 | 3 | 0 | 4 | 8 |
| Golgi | 0 | 0 | 0 | 0 | 0 | 0 | 0 | 0 | 0 | 0 | 0 | 0 | – | 0 | 0 | – | – | 3 | 0 | 1 | 3 | 0 | 1 | 2 |
| Mitochondria | 0 | 4 | 2 | 11 | 11 | 40 | 66 | 112 | 102 | 165 | 171 | 131 | – | 0 | 0 | – | – | 7 | 17 | 7 | 25 | 27 | 22 | 25 |
| Nucleus | 0 | 0 | 0 | 2 | 0 | 2 | 1 | 1 | 2 | 1 | 0 | 1 | – | 0 | 1 | – | – | 0 | 0 | 0 | 0 | 0 | 0 | 0 |
| Nuclear Periphery | 0 | 2 | 0 | 0 | 0 | 1 | 0 | 0 | 1 | 0 | 1 | 0 | – | 0 | 0 | – | – | 0 | 0 | 0 | 0 | 0 | 0 | 0 |
| Nucleolus | 0 | 0 | 1 | 1 | 0 | 1 | 0 | 1 | 3 | 2 | 1 | 1 | – | 0 | 0 | – | – | 1 | 0 | 0 | 0 | 0 | 0 | 0 |
| Peroxisomes | 0 | 0 | 2 | 6 | 16 | 1 | 0 | 2 | 2 | 4 | 1 | 2 | – | 0 | 0 | – | – | 1 | 0 | 0 | 1 | 0 | 1 | 4 |
| SpindlePole | 0 | 0 | 3 | 1 | 4 | 0 | 2 | 1 | 1 | 5 | 1 | 2 | – | 0 | 0 | – | – | 3 | 1 | 0 | 0 | 0 | 0 | 0 |
| Vac/Vac Membrane | 3 | 0 | 5 | 1 | 13 | 12 | 15 | 6 | 4 | 5 | 2 | 7 | – | 0 | 0 | – | – | 4 | 75 | 27 | 31 | 12 | 11 | 23 |
| Unique Cell Count | 348 | 183 | 294 | 237 | 339 | 308 | 386 | 481 | 314 | 506 | 369 | 382 | 36 | 125 | 440 | 403 | 200 | 303 | 119 | 155 | 235 | |||
| Labelled Cell Count | 360 | 193 | 318 | 265 | 381 | 362 | 445 | 552 | 378 | 606 | 466 | 468 | 41 | 137 | 486 | 403 | 200 | 303 | 119 | 155 | 235 | |||
Yeast GFP Assignment
Protein Abundance
| Screen | WT1 | WT2 | WT3 | RAP60 | RAP140 | RAP220 | RAP300 | RAP380 | RAP460 | RAP540 | RAP620 | RAP700 | HU80 | HU120 | HU160 | rpd3Δ_1 | rpd3Δ_2 | rpd3Δ_3 | AF100 | AF140 | AF180 |
|---|---|---|---|---|---|---|---|---|---|---|---|---|---|---|---|---|---|---|---|---|---|
| Mean Cell GFP Intensity (1e-4) | 5.4 | 5.4 | 5.5 | 5.4 | 5.7 | 4.7 | 4.4 | 4.7 | 4.3 | 4.1 | 4.0 | 4.1 | – | 5.6 | 5.9 | 4.7 | 4.8 | 6.1 | 5.7 | 6.4 | 6.8 |
| Std Deviation (1e-4) | 0.6 | 0.8 | 1.8 | 1.4 | 2.2 | 1.4 | 0.9 | 1.6 | 1.2 | 1.1 | 1.3 | 0.8 | – | 0.9 | 0.5 | 1.3 | 1.3 | 1.9 | 1.6 | 1.5 | 1.5 |
| Intensity Change (Log2) | – | – | – | -0.02 | 0.06 | -0.23 | -0.34 | -0.23 | -0.34 | -0.43 | -0.46 | -0.43 | – | 0.03 | 0.09 | -0.23 | -0.19 | 0.15 | 0.05 | 0.22 | 0.31 |
Localization Change
| Localization | RAP60 | RAP140 | RAP220 | RAP300 | RAP380 | RAP460 | RAP540 | RAP620 | RAP700 | HU80 | HU120 | HU160 | rpd3Δ_1 | rpd3Δ_2 | rpd3Δ_3 |
|---|---|---|---|---|---|---|---|---|---|---|---|---|---|---|---|
| Cortical Patches | 0 | 0 | 0 | 0 | 0 | 0 | 0 | 0 | 0 | – | 0 | 0 | – | – | 0 |
| Bud | 2.0 | 0 | 0 | 0 | 0 | 0 | 0 | 0 | 0 | – | 0 | 0 | – | – | 0 |
| Bud Neck | 0 | 0 | 0 | 0 | 0 | 0 | 0 | 0 | 0 | – | 0 | 0 | – | – | 0 |
| Bud Site | 0 | 0 | 0 | 0 | 0 | 0 | 0 | 0 | 0 | – | 0 | 0 | – | – | 0 |
| Cell Periphery | 1.0 | 0.6 | 0 | 0 | 0 | 0 | 0 | 0 | 0 | – | 0 | 3.2 | – | – | -1.4 |
| Cytoplasm | -1.3 | -1.4 | -2.8 | -3.0 | -4.9 | -5.8 | -5.7 | -7.2 | -6.5 | – | 2.1 | 1.2 | – | – | 3.6 |
| Endoplasmic Reticulum | -1.4 | -0.8 | 0 | 0 | 0 | 0 | 0 | 0 | 0 | – | 0 | 0 | – | – | 1.4 |
| Endosome | 0.1 | 0.4 | 0 | 0 | 0 | 0 | 0 | 0 | 0 | – | 0 | 0 | – | – | -3.2 |
| Golgi | 0 | 0 | 0 | 0 | 0 | 0 | 0 | 0 | 0 | – | 0 | 0 | – | – | 0 |
| Mitochondria | 2.9 | 2.3 | 0 | 0 | 0 | 0 | 0 | 0 | 0 | – | 0 | 0 | – | – | 0 |
| Nucleus | 0 | 0 | 0 | 0 | 0 | 0 | 0 | 0 | 0 | – | 0 | 0 | – | – | 0 |
| Nuclear Periphery | 0 | 0 | 0 | 0 | 0 | 0 | 0 | 0 | 0 | – | 0 | 0 | – | – | 0 |
| Nucleolus | 0 | 0 | 0 | 0 | 0 | 0 | 0 | 0 | 0 | – | 0 | 0 | – | – | 0 |
| Peroxisomes | 0 | 3.0 | 0 | 0 | 0 | 0 | 0 | 0 | 0 | – | 0 | 0 | – | – | 0 |
| SpindlePole | 0 | 0 | 0 | 0 | 0 | 0 | 0 | 0 | 0 | – | 0 | 0 | – | – | 0 |
| Vacuole | 0 | 1.6 | 1.6 | 1.7 | 0 | 0 | 0 | 0 | 0.1 | – | 0 | 0 | – | – | 0 |
External localization resources
Images






























Protein Concentration and Protein Localization Data
| R1 | R2 | R3 | ||||||||||||||||
|---|---|---|---|---|---|---|---|---|---|---|---|---|---|---|---|---|---|---|
| G1 Pre-START | G1 Post-START | S/G2 | Metaphase | Anaphase | Telophase | G1 Pre-START | G1 Post-START | S/G2 | Metaphase | Anaphase | Telophase | G1 Pre-START | G1 Post-START | S/G2 | Metaphase | Anaphase | Telophase | |
| Concentration | – | – | – | – | – | – | – | – | – | – | – | – | – | – | – | – | – | – |
| Actin | 0.0347 | 0.0145 | 0.0269 | 0.0136 | 0.0145 | 0.0096 | 0.0713 | 0.0032 | 0.0078 | 0.002 | 0.0126 | 0.0042 | 0.0026 | 0.017 | 0.0011 | 0.0022 | 0.0005 | 0.0003 |
| Bud | 0.0026 | 0.0027 | 0.0092 | 0.0134 | 0.0012 | 0.0012 | 0.0009 | 0.0007 | 0.0013 | 0.0001 | 0.0003 | 0.0003 | 0.0005 | 0.0065 | 0.0009 | 0.0005 | 0.0001 | 0 |
| Bud Neck | 0.0109 | 0.0006 | 0.0025 | 0.0024 | 0.0058 | 0.0028 | 0.0022 | 0.0008 | 0.0013 | 0.0014 | 0.0004 | 0.0053 | 0.0005 | 0.0011 | 0.0138 | 0.0003 | 0.0004 | 0.0004 |
| Bud Periphery | 0.0057 | 0.0073 | 0.0039 | 0.0404 | 0.0018 | 0.0011 | 0.0017 | 0.0015 | 0.0033 | 0.0003 | 0.0006 | 0.0008 | 0.0005 | 0.0107 | 0.0025 | 0.0023 | 0.0002 | 0 |
| Bud Site | 0.0132 | 0.0182 | 0.0137 | 0.0121 | 0.0036 | 0.0007 | 0.0051 | 0.0118 | 0.0071 | 0.0005 | 0.0006 | 0.0037 | 0.003 | 0.072 | 0.0079 | 0.0003 | 0.0002 | 0.0001 |
| Cell Periphery | 0.0024 | 0.0016 | 0.0018 | 0.0023 | 0.001 | 0.0004 | 0.0025 | 0.0025 | 0.0055 | 0.0017 | 0.0004 | 0.0009 | 0.0039 | 0.0084 | 0.0138 | 0.0043 | 0.0006 | 0.0006 |
| Cytoplasm | 0.2989 | 0.461 | 0.425 | 0.357 | 0.4038 | 0.4289 | 0.3929 | 0.5497 | 0.5264 | 0.5801 | 0.6714 | 0.5989 | 0.5106 | 0.5988 | 0.651 | 0.273 | 0.714 | 0.4946 |
| Cytoplasmic Foci | 0.0358 | 0.018 | 0.0181 | 0.0508 | 0.058 | 0.0285 | 0.0353 | 0.0185 | 0.01 | 0.0112 | 0.0291 | 0.0145 | 0.0031 | 0.051 | 0.0063 | 0.0062 | 0.0044 | 0.0101 |
| Eisosomes | 0.0008 | 0.0003 | 0.0006 | 0.0003 | 0.0002 | 0.0001 | 0.0012 | 0.0004 | 0.0004 | 0.0002 | 0.0001 | 0.0002 | 0.0001 | 0.0007 | 0.0002 | 0.0005 | 0 | 0 |
| Endoplasmic Reticulum | 0.0326 | 0.0276 | 0.0217 | 0.0132 | 0.0125 | 0.0126 | 0.0331 | 0.0307 | 0.0335 | 0.0151 | 0.0264 | 0.0299 | 0.0131 | 0.0572 | 0.1104 | 0.0061 | 0.006 | 0.0435 |
| Endosome | 0.0252 | 0.0058 | 0.0128 | 0.0322 | 0.0338 | 0.0136 | 0.0301 | 0.0121 | 0.0067 | 0.0054 | 0.0244 | 0.0036 | 0.0207 | 0.0141 | 0.0081 | 0.0021 | 0.0007 | 0.0052 |
| Golgi | 0.008 | 0.0009 | 0.0063 | 0.0113 | 0.0137 | 0.0041 | 0.0073 | 0.003 | 0.002 | 0.0064 | 0.0069 | 0.0007 | 0.0007 | 0.0018 | 0.0019 | 0.0005 | 0.0001 | 0.0003 |
| Lipid Particles | 0.0144 | 0.0025 | 0.0108 | 0.0132 | 0.0287 | 0.0114 | 0.0136 | 0.0091 | 0.0051 | 0.009 | 0.0265 | 0.0028 | 0.0014 | 0.0306 | 0.0042 | 0.0012 | 0.0002 | 0.0025 |
| Mitochondria | 0.0073 | 0.0008 | 0.0035 | 0.0086 | 0.0072 | 0.0046 | 0.0035 | 0.0021 | 0.0054 | 0.0017 | 0.0027 | 0.0005 | 0.0042 | 0.0003 | 0.0014 | 0.0012 | 0 | 0.0001 |
| None | 0.4426 | 0.4157 | 0.4248 | 0.3724 | 0.3792 | 0.4496 | 0.363 | 0.3285 | 0.3726 | 0.3544 | 0.1611 | 0.3266 | 0.0124 | 0.1192 | 0.1364 | 0.6919 | 0.2696 | 0.4387 |
| Nuclear Periphery | 0.0157 | 0.002 | 0.0015 | 0.0039 | 0.0046 | 0.0033 | 0.0082 | 0.0015 | 0.0019 | 0.0007 | 0.0026 | 0.001 | 0.1718 | 0.0022 | 0.0027 | 0.0011 | 0.0005 | 0.001 |
| Nucleolus | 0.0016 | 0.0006 | 0.0009 | 0.0035 | 0.0004 | 0.0006 | 0.001 | 0.0008 | 0.0006 | 0.0002 | 0.0001 | 0.0002 | 0.0048 | 0.0004 | 0.0013 | 0.0003 | 0.0001 | 0 |
| Nucleus | 0.0063 | 0.0019 | 0.0029 | 0.0063 | 0.0013 | 0.0022 | 0.0045 | 0.0019 | 0.0013 | 0.0006 | 0.0014 | 0.0009 | 0.2131 | 0.0015 | 0.0017 | 0.0007 | 0.0008 | 0.0004 |
| Peroxisomes | 0.0157 | 0.0037 | 0.0054 | 0.0166 | 0.0218 | 0.0115 | 0.012 | 0.0146 | 0.0019 | 0.0067 | 0.0283 | 0.0018 | 0.0003 | 0.0003 | 0.0002 | 0.0003 | 0 | 0 |
| Punctate Nuclear | 0.0162 | 0.0087 | 0.002 | 0.0117 | 0.0026 | 0.0107 | 0.0074 | 0.0015 | 0.0014 | 0.0004 | 0.0012 | 0.0016 | 0.0155 | 0.002 | 0.0004 | 0.0004 | 0.0004 | 0.0005 |
| Vacuole | 0.0075 | 0.0053 | 0.0053 | 0.0123 | 0.0034 | 0.0023 | 0.0026 | 0.0047 | 0.0042 | 0.0017 | 0.0026 | 0.0015 | 0.0099 | 0.0043 | 0.031 | 0.0043 | 0.0011 | 0.0015 |
| Vacuole Periphery | 0.002 | 0.0003 | 0.0007 | 0.0026 | 0.0012 | 0.0004 | 0.0008 | 0.0004 | 0.0003 | 0.0001 | 0.0004 | 0.0001 | 0.0074 | 0.0002 | 0.0027 | 0.0004 | 0 | 0.0001 |
Sequencing Data
| R1 | R2 | |||||||||
|---|---|---|---|---|---|---|---|---|---|---|
| G1 Post-START | S/G2 | Metaphase | Anaphase | Telophase | G1 Post-START | S/G2 | Metaphase | Anaphase | Telophase | |
| Gene Expression | 14.3363 | 10.9008 | 14.4288 | 15.7668 | 14.742 | 12.5168 | 15.8625 | 16.0843 | 15.6373 | 18.0648 |
| Translational Efficiency | 0.2692 | 0.2739 | 0.2912 | 0.2591 | 0.2091 | 0.3125 | 0.277 | 0.1968 | 0.2536 | 0.2112 |
Hit Data
| Dataset | Hit |
|---|---|
| Protein Concentration | – |
| Protein Localization | ✘ |
| Gene Expression | ✘ |
| Translational Efficiency | ✘ |
Endocytosis
| Temp | Actin Patch (Sac6-tdTomato) | Cortical Patch (Sla1-GFP) | Late Endosome (Snf7-GFP) | Vacuole (Vph1-GFP) |
|---|---|---|---|---|
| 37℃ | ||||
| RT |
Cell Cycle Omics
CYCLoPs (Ire1-GFP)
| Gene / Allele | Actin Patch (Sac6-tdTomato) | Cortical Patch (Sla1-GFP) | Late Endosome (Snf7-GFP) | Vacuole (Sac6-tdTomato) |
|---|
| Gene | Images |
|---|
| Gene | Images |
|---|
Images are not yet available
Images are not yet available